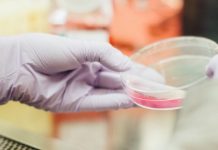

Hombre dispara a bebé tras sufrir rechazo de su madre
Fresno, California.- Un hombre disparó a una bebé de diez meses en la cabeza después de que la madre de la menor...
Hombres más propensos a cáncer de próstata si en familia hubo cáncer de mama
Los varones con antecedentes familiares de cáncer de mama tienen el doble riesgo de padecer cáncer de próstata, señaló este lunes un experto.
José...
Pixar y un mismo universo
Desde hace años circula la creencia entre los fans de que las películas de Pixar se desarrollan en el mismo universo; esto después...
Scamp se corona como el perro más feo del mundo 2019
Scamp, un perro con rastas se llevó los máximos honores el pasado viernes en la edición 31 del concurso anual de perros más...
“Toy Story 4” se apodera de la taquilla el fin de semana
Pese a tener una recaudación menor a la esperada en su fin de semana de estreno, Toy Story 4 logró apoderarse de la taquilla en Estados...
Con grato festejo concluye un año más de actividades de ANSPAC
Coatepec, Ver.- Con gran éxito concluyó un ciclo más de los talleres de la Asociación Nacional Pro-superación Personal A.C. (ANSPAC) cuya titular...
Acusan a Cardi B de agresión grave por pelea en bar de Nueva York
La rapera Cardi B fue condenada por un gran jurado en un caso que la involucra en una pelea en un bar de strippers,...
Preservativos semáforos, cambian de color si detecta enfermedades
CIUDAD DE MÉXICO.- Los condones semáforo han causado furor en redes, ya que estos preservativos al parecer cambian de color dependiendo de la...
Carlos Trejo se declara listo para pelea con Alfredo Adame
El “cazafantasmas” Carlos Trejo anunció en redes sociales que ya está listo para la pelea de artes marciales mixtas que sostendrá en un par de meses con...
Apple advierte por baterías de MacBook Pro que pueden sobrecalentarse
Apple llamó este jueves a revisión voluntaria equipos MacBook Pro vendidos entre septiembre de 2015 y febrero de 2017 al haber detectado riesgos de...